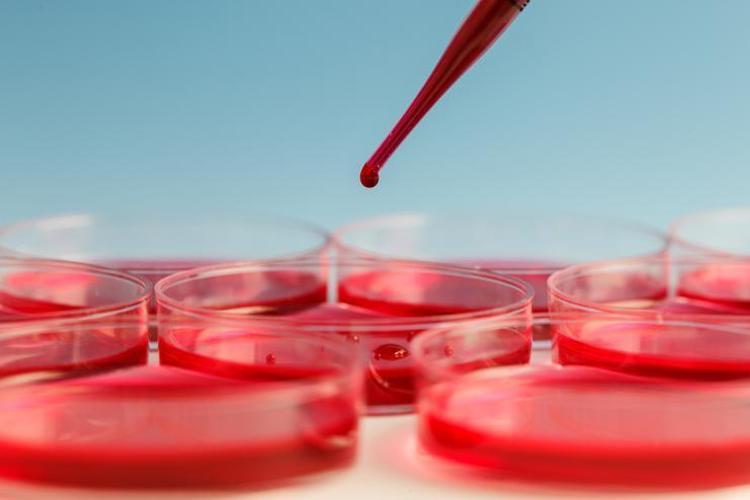
Anemi nedir Anemi belirtileri nelerdir

Anemi hangi hastalıkların habercisi? Anemi tedavisi

Tüm dünyada yaşam tarzlarını ve öncelikleri değiştiren, süreç uzadıkça ne zaman son bulacağı merak konusu olan COVID-19 salgını hepimizin hayatını etkiliyor. İleri yaş ve kronik hastalığı olanların önlemlere çok daha dikkat etmesi her alanda sıkça tekrarlanıyor. Özelikle kadınların yaşamlarında bir dönem ilaç veya destek alması gerektiği anemi yani kansızlığın bu salgın sürecinde göz ardı edilebildiğine dikkat çeken Liv Hospital Ulus Hematoloji Uzmanı Doç. Dr. Mehmet Hilmi Doğu anemiye neden olabilecek durumları ve tedavisi anlattı.
Anemi nedir? Anemi belirtileri nelerdir?
Dokulara yeterli oksijen taşınması için gerekli kırmızı kan hücrelerinde azalma olarak tanımlanan anemi; vücutta yorgunluk, halsizlik, baş dönmesi, çarpıntı hissi, uyuşmalar, el ve ayaklarda üşüme hissi gibi şikayetlere neden olabilir.
Aneminin sebebi ve derinliğine göre konsantrasyon eksikliği, uyku hali yanında saç dökülmesi, tırnak kırılması gibi sayılabilecek daha birçok şikayet sıralanabilir. Günlük aktivitelerimizde kısıtlamalara sebep olabilir.

Anemi denince aklımıza sıklıkla demir eksikliği gelir. Ancak unutulmaması gereken önemli bir nokta anemi bir sonuç olup anemiye neden olabilecek birçok farklı durum olabilir. Demir dışında B12 vitamini ve folik asitte kan üretimi için gereklidir ve eksikliği anemiye neden olabilir.
Ayrıca aneminin sebebi bazen zeminde yatan kronik hastalıklar, sık tekrarlayan kanamalar daha da önemlisi mide kanseri, kolon kanseri, kemik iliği ile alakalı bir hastalık olabilir.

Aneminin nedenine göre tedavi belirlemeli
Anemide tedavi seçeneği belirlenirken anemi nedeninin kesinlikle aydınlatılması gerekir. Bazen demir gibi B12 vitamini gibi basit eksik olanı yerine koyarak kolaylıkla düzeltilebilirken, bazen de ileri tetkikler ile altta yatan hastalığın tespiti ve bu hastalığa yönelik tedavi gerekir.
Anemi sıkça karşılaşılması, bazı hastalarımızın tekrarlayan süreçler yaşaması nedeniyle önemini yitiriyor ve göz ardı edilebiliyor. Hem uygun tedavi ile şikayetlerin azaltılması hem de gerektiğinde ileri tetkikler ile altta yatan ciddi olabilecek rahatsızlıkların erken tanısı adına asla ihmal edilmemesi gerekir.